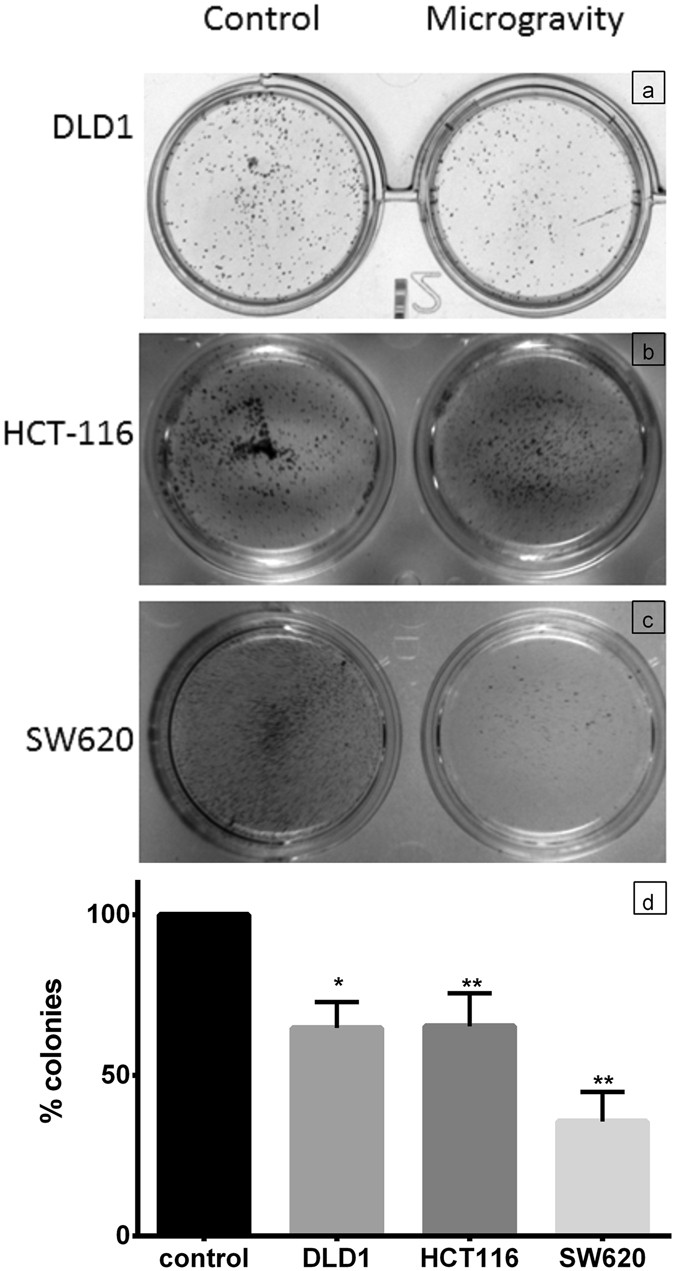
Figure 4

Figure 4
Cell growth is hindered with SM which results in reduced colony formation. The phase contrast image of colonies formed with 1000 cells in a 24 well plate for control and SM cells of DLD1 (a), HCT116 (b) and SW620 (c) show the reduced number of colonies in simulated microgravity. The data representation as mean + S.D. (d) depicts the reduction in percentage of colonies formed. The experiment was repeated thrice, data shows that colony formation was significantly reduced. P < 0.005 for HCT 116 and SW620, while P < 0.05 for DLD1.
